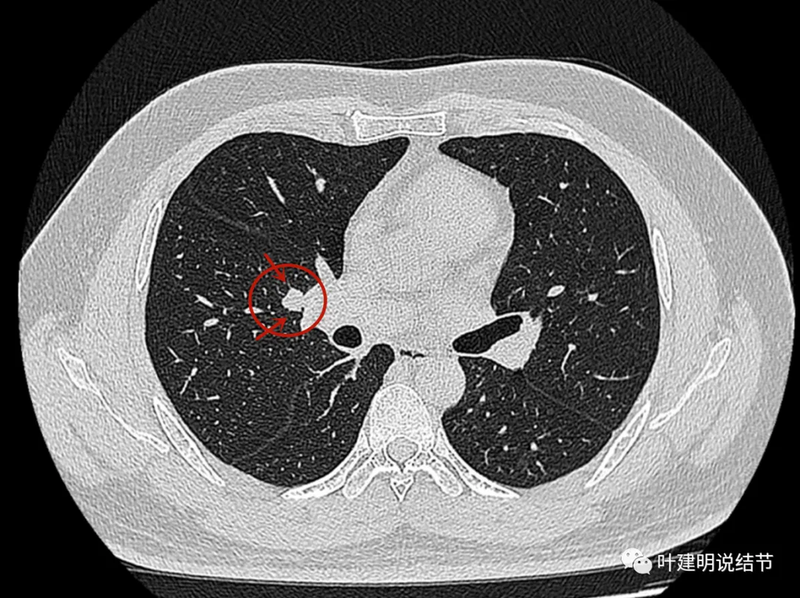
图片

前言:肺实性结节最纠结的莫过于:实性密度,位置靠中央若手术要切肺叶,再加上随访进展并不明显,边缘较为平整的病灶!因为不手术怕肺癌,实性的耽误了影响预后;手术要切除组织多,基本得肺叶切除,良性则又可惜!怎么办?今天分享的这位结友也是这样的情况,而且往往这种情况你问诊多位医生,意见又容易是不一致的,这时候就更难了!那我们要怎样来进行临床的思维考虑?我们之前又有过怎样的经验可供借鉴呢?
病史信息:
基本信息:
女性, 72岁。
主诉:
发现肺结节半年。
现病史:
患者2023年年底检查肺部CT发现大小为1.9左右的肺部实性结节,未予治疗,3月后复查增强CT提示未见明显变化。2024-5查薄层肺ct未见变化,医生建议半年后复查,患者偶有咳嗽,无其他不适,特来咨询就诊。
希望获得的帮助:
去年年底有做肺部ct,发现有一个1.9左右的肺部实性结节。三个月后就是今年2月底又做了增强ct,没有变化。5月底做了薄ct,也是没有变化。当地医生给出,半年后再复查。想给叶医生看看,好心安。
影像展示与分析:
先看患者提供的2024年2月份的CT影像:

病灶出现,在右下叶支气管旁边,轮廓清楚,此层似磨玻璃密度。

表面似分叶状,密度不纯,邻近血管略有弯曲向病灶。

实性密度,边缘光滑,与背段支气管亚段贴着。

天蓝色箭头示病灶与支气管之间有缝隙,但贴的较近;黄色箭头示支气管管腔;红色箭头示病灶,边缘光滑。

支气管受压,但无明显破坏;与支气管之间紧贴位有的位置仍有缝隙;病灶边缘光滑。

病灶密度较为均匀,对支气管是压迫后移位。表面光滑。

似乎有血管穿过。

边缘光滑,没有毛刺,膨胀性生长。

表面光滑,内部密度较均匀,边界清楚,膨胀性长。

没有侵犯邻近支气管。

边缘光滑,分叶不明显。

上图这个层面感觉病灶与肺血管之间没有明显间隙,似像侵犯或愈着的样子。

结节边缘区域与血管之间又有间隙了的。

下肺静脉水平,病灶基本没有了。
再看2024年5月时复查的影像:

分叶,混合偏实性密度,血管贴边走行。

与支气管紧贴,黄色箭头所示处似乎支气管壁与病灶已经愈着。

上图又见结节与支气管不是都愈着的,说明侵袭性并不强,病灶表面光滑。

天蓝色箭头所指处是北段支气管与病灶之间,感觉较2月份贴得近了一点点。病灶表面仍是光滑的,总体感觉有膨胀性。

病灶边缘光滑,有血管穿出来似的。

表面光滑,有膨胀性。

内部密度较为均匀,就位于肺门部。

边缘光滑,实性,有膨胀感。

与血管关系近。

边缘区域与下肺静脉间隙不太清楚。
我的意见:
右肺下叶这个病灶从连续的层面看,连续较为光滑、有一定膨胀性,部分表面有浅分叶,病灶内部无明显钙化,随访无显著变化(当然时间还短),没有明显侵犯邻近血管或支气管,但紧贴、关系密切。我之前碰到好几例类似的实性小结节随访没有明显进展的,最后证实是低分化腺癌的,我还有专门在公众号总结过这类病例的影像特点。我个人觉得仍然恶性不能够除外。如果不是恶性,那么错构瘤或者良性肿瘤的话,手术的时候肺的表面切开一剥就出来了。通过比较小的一个手术就能把病灶拿掉,而且明确了诊断。如果确实是实质性的非良性的肿瘤,那么他如果往旁边生产侵犯很容易就影响到血管。个人感觉利弊综合考虑还是手术探查更加稳妥。意见供参考!
感悟:
这个病例在结友女儿问诊我之后,我是建议她开刀为妥,因为考虑恶性的可能性不能排除,而且真恶性则风险较大,真若错构瘤则手术并不需要切除肺叶。但后面家属带她到某省级医院看了大专家,教授告诉她良性的,不需要开刀,老人很高兴。她女儿说,也就没有办法再告诉她妈妈这个病灶也不能除外恶性,或仍有医生是建议开刀的。但愿吧!希望真不是恶性,那最理想。我倒是真的不放心的,下面这几例都是恶性的,你说能安心吗?
病例1:

病例2:


病例3:

病例4:

病例5:


右上实性病灶是神经内分泌癌,考虑典型类癌。